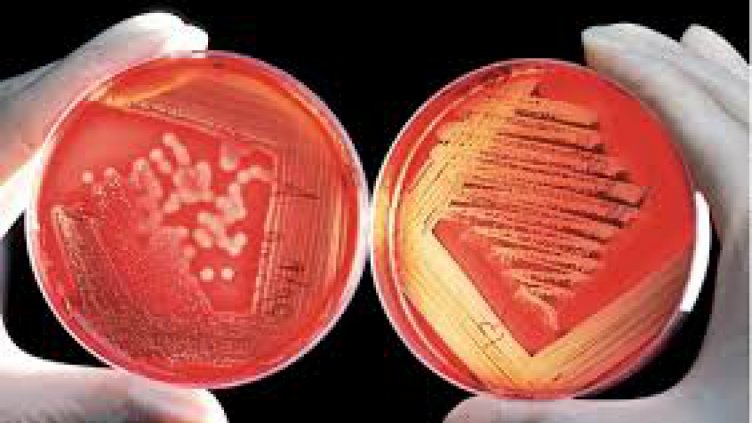
Хората с нулева кръвна група изкарват по-леко коронавируса

Хората с нулева кръвна група изкарват по-леко коронавируса. Това обясни пред НОВА мунологът доц. д-р Велизар Шиваров.
Той посочи, че има сериозно доказателство за влиянието на кръвната група при заразяване с коронавирус. "Това е проучване от Италия и Испания. При генетичния вариант, който определя кръвна група "0" има по-нисък риск. Ако сте нулева кръвна група, имате по-малък риск да се разболеете от COVID-19. По-малък е и рискът заболяването да протече по-тежко", заяви медикът.
Според него откриването на ваксина срещу коронавируса би било огромно постижение. "Първите регистрации биха могли да се случат в края на тази и началото на следващата година. Това би било постижение", смята Шиваров и допълни, че периодът за набиране на данни е твърде малък за дългосрочна ефикасност. "Контролът ще бъде резултат не само на ваксина, но и на спазване на хигиенните навици.", уточни имунологът.
В сезона, в който върлува освен коронавирусът, но и грипните вируси, специалистът препоръча избягването на рискови контакти. Препоръча да се прекарва и повече време на слънце, за да може организма да се снабди с Витамин D.
"Няма нещо, което да е доказано като проста мярка освен носенето на маска и спазването на дистанция, предпазващи от коронавируса", добави той.
Д-р Шиваров коментира и противоепидемичните мерки, като обясни, че разпускането им не е грешка. "Още в началото на кризата имаше математическо моделиране за възможните сценарии. и един от най-вероятните беше с периодично затягане и разпускане на мерките, за да се постигне баланс между икономически, социален живот и здравни последици.", заяви лекарят.
Той призова, че ако човек има симптоми или съмнения, не трябва да експериментира с лекарства, а да потърси медицинска помощ.
Прочети още на: https://www.dnes.bg/stranata/2020/09/27/horata-s-opredelena-kryvna-grupa-izkarvat-po-leko-koronavirusa.464148

"Fallway" с Емили Влайкова – филм за вредата от наркотиците и ползите от спорта
"Fallway" с Емили Влайкова – филм за вредата от наркотиците и ползите от спорта  AI и фалшивите имейли: Как да се пазим в ерата на онлайн измамите (ВИДЕО)
AI и фалшивите имейли: Как да се пазим в ерата на онлайн измамите (ВИДЕО)  "Лудогорец" обяви раздялата с Руи Мота и новия треньор
"Лудогорец" обяви раздялата с Руи Мота и новия треньор  Защо не използваме дефибрилаторите? Кампания за първа помощ спасява животи
Защо не използваме дефибрилаторите? Кампания за първа помощ спасява животи 
 Микроби от облаците ще помагат в търсенето на живот на други планети
Микроби от облаците ще помагат в търсенето на живот на други планети  Повечето пластмаса, попаднала в океана, не плава на повърхността: Къде изчезва?
Повечето пластмаса, попаднала в океана, не плава на повърхността: Къде изчезва?  Загадъчно: Свързват появата на ярки точки в небето с периодите на ядрени опити
Загадъчно: Свързват появата на ярки точки в небето с периодите на ядрени опити  За първи път заснеха изхвърляне на плазма от звезда – аналог на Слънцето
За първи път заснеха изхвърляне на плазма от звезда – аналог на Слънцето 
 Интер назначи психолог за вратаря убил инвалид
Интер назначи психолог за вратаря убил инвалид  Спалети пристига днес в Торино, представят го утре
Спалети пристига днес в Торино, представят го утре  Конте: Надявам се оплакванията да не повлияят на съдиите
Конте: Надявам се оплакванията да не повлияят на съдиите  ОФИЦИАЛНО: Лудогорец призна за треньорската рокада
ОФИЦИАЛНО: Лудогорец призна за треньорската рокада 
 Хапвайте райски ябълки за щитовидната жлеза и при високо кръвно
Хапвайте райски ябълки за щитовидната жлеза и при високо кръвно  3 рецепти за лесен протеинов обяд
3 рецепти за лесен протеинов обяд  6 напитки за баланс на кръвната захар
6 напитки за баланс на кръвната захар  Театър „София“ пуска билети с 50% намаление за Деня на будителите
Театър „София“ пуска билети с 50% намаление за Деня на будителите 
 Какво всъщност стои зад целулита?
Какво всъщност стои зад целулита?  Какво се случва в мозъка по време на инсулт?
Какво се случва в мозъка по време на инсулт?  Д-р Александар Маринков: При почти 2/3 от пациентите изявата на псориазис предхожда симптомите на псориатичен артрит
Д-р Александар Маринков: При почти 2/3 от пациентите изявата на псориазис предхожда симптомите на псориатичен артрит  Честотата на мозъчния инсулт нараства многократно след 70-годишна възраст
Честотата на мозъчния инсулт нараства многократно след 70-годишна възраст 
 дава под наем, Двустаен апартамент, 68 m2 Варна, Чайка, 664.68 EUR
дава под наем, Двустаен апартамент, 68 m2 Варна, Чайка, 664.68 EUR  дава под наем, Къща, 120 m2 Варна, м-т Сотира, 1700 EUR
дава под наем, Къща, 120 m2 Варна, м-т Сотира, 1700 EUR  дава под наем, Тристаен апартамент, 68 m2 Варна, Жп Гара, 511.29 EUR
дава под наем, Тристаен апартамент, 68 m2 Варна, Жп Гара, 511.29 EUR  дава под наем, Двустаен апартамент, 55 m2 Варна, Център, 460 EUR
дава под наем, Двустаен апартамент, 55 m2 Варна, Център, 460 EUR 










 Японският индекс Nikkei 225 премина границата от 51 000 пункта за първи път
Японският индекс Nikkei 225 премина границата от 51 000 пункта за първи път  Продажбата на "Лукойл" минава през САЩ – възможни купувачи са SOCAR и Cengiz Holding
Продажбата на "Лукойл" минава през САЩ – възможни купувачи са SOCAR и Cengiz Holding  AI да продава на AI e следващото ниво на онлайн пазаруването
AI да продава на AI e следващото ниво на онлайн пазаруването  Боят над Берое няма да успокои обстановката в ЦСКА
Боят над Берое няма да успокои обстановката в ЦСКА  Бум от кражби на Toyota заради недоглеждане на производителя
Бум от кражби на Toyota заради недоглеждане на производителя  Като магьосница – Памела Андерсън привлече погледите с най-дивия си тоалет досега
Като магьосница – Памела Андерсън привлече погледите с най-дивия си тоалет досега  Лиам Хемсуърт най-сетне проговори за годежа си
Лиам Хемсуърт най-сетне проговори за годежа си
Коментари